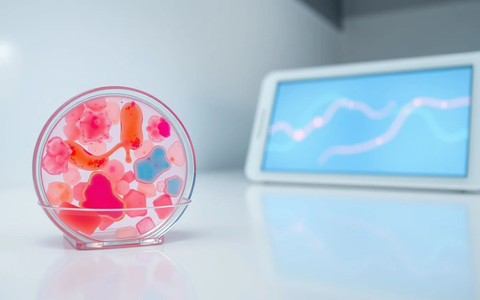

Darmgesundheit: Neue Tests revolutionieren die Prävention
13.10.2025 - 19:05:02 | boerse-global.deEin vielfältiges Darmmikrobiom entscheidet über Gesundheit und Wohlbefinden. Moderne Diagnostik macht individuelle Präventionsstrategien möglich und leitet eine neue Ära der personalisierten Medizin ein.
Die Bedeutung des Darms für die Gesundheit rückt immer stärker in den Fokus. Was früher nur als Verdauungsorgan galt, entpuppt sich als zentrale Schaltstelle für Immunsystem, Psyche und Krankheitsprävention. Das Darmmikrobiom – die Gemeinschaft von Billionen Mikroorganismen in unserem Darm – beeinflusst weit mehr als nur die Verdauung.
Aktuelle Forschungen zeigen: Störungen im komplexen Darm-Ökosystem stehen mit zahlreichen Erkrankungen in Verbindung. Von Stoffwechselstörungen bis hin zu Parkinson und Alzheimer – ein gestörtes Mikrobiom kann der Auslöser sein. Diese Erkenntnisse treiben die Entwicklung innovativer Testverfahren voran, die weit über herkömmliche Methoden hinausgehen.
Wenn der Bauch mit dem Kopf spricht
Die faszinierendste Entdeckung der letzten Jahre: die Darm-Hirn-Achse. Diese komplexe Kommunikationsverbindung funktioniert in beide Richtungen und beeinflusst Emotionen, Verhalten und sogar kognitive Funktionen.
Darmbakterien produzieren Botenstoffe wie kurzkettige Fettsäuren und Neurotransmitter, die direkt auf das Nervensystem wirken. Forschungen der Konferenz Probiota 2025 lieferten konkrete Belege: Gezielte Eingriffe in das Mikrobiom können das psychische Wohlbefinden über definierte Stoffwechselwege beeinflussen.
Eine gestörte Darmflora wird daher zunehmend mit Depressionen, Angststörungen und neurologischen Erkrankungen verknüpft. Der Bauch denkt also tatsächlich mit.
Anzeige: Passend zur Darm-Hirn-Achse: Möchten Sie Ihre Konzentration und Ihr Gedächtnis gezielt stärken? Der kostenlose PDF‑Ratgeber „Gehirntraining leicht gemacht“ liefert 7 Geheimnisse, 11 alltagstaugliche Übungen und einen Selbsttest – ohne teure Mittel und sofort umsetzbar. Starten Sie noch heute mit kurzen Routinen für mehr mentale Fitness. Jetzt den Gratis‑Report „Gehirntraining leicht gemacht“ sichern
Revolution in der Diagnostik
Herkömmliche Stuhltests kratzen nur an der Oberfläche. Moderne Verfahren wie die Shotgun-Metagenom-Sequenzierung revolutionieren die Darmdiagnostik. Diese Technologie analysiert die gesamte genetische Information aller Darmmikroorganismen.
Das Ergebnis: Ärzte sehen nicht nur, welche Bakterienarten vorhanden sind, sondern auch deren Funktionen und Aktivität. Innovative Ansätze gehen noch weiter und analysieren Stoffwechselprodukte im Blut, um ein genaues Bild der Darmaktivität zu erhalten.
Diese detaillierten Analysen ermöglichen erstmals eine wirklich personalisierte Prävention. Individuelle Ungleichgewichte werden sichtbar, die mit allgemeinen Ratschlägen nie zu erkennen wären.
Maßgeschneiderte Therapien statt Einheitslösung
Das Ziel: weg von Standardempfehlungen, hin zu individuell zugeschnittenen Strategien. Basierend auf der Mikrobiomanalyse entstehen Ernährungsempfehlungen, die gezielt das Wachstum nützlicher Bakterien fördern.
Präbiotika wie Inulin dienen als „Futter“ für gesunde Darmbakterien. Eine Studie der Universität Wien zeigte jedoch: Die Reaktion auf Präbiotika variiert von Person zu Person erheblich. Was bei einem hilft, kann bei einem anderen wirkungslos bleiben.
Neben der Ernährung rücken Probiotika (lebende nützliche Bakterien), Synbiotika (Kombinationen aus Pro- und Präbiotika) und sogar Postbiotika (Bakterien-Stoffwechselprodukte) in den Fokus personalisierter Gesundheitsstrategien.
Paradigmenwechsel in der Medizin
Die Entwicklungen markieren einen grundlegenden Wandel: von der Symptombehandlung zur proaktiven, personalisierten Prävention. Die Erkenntnis, dass es „den einen“ gesunden Darm nicht gibt, stellt standardisierte Ansätze in Frage.
Der Markt für Mikrobiomanalysen und personalisierte Nahrungsergänzungsmittel wächst rasant. Verbraucher greifen verstärkt zu funktionellen Lebensmitteln wie Joghurt, Kefir und ballaststoffreichen Produkten.
Experten warnen jedoch: Noch ist viel Forschungsarbeit nötig, um die komplexen Zusammenhänge vollständig zu verstehen. Die Herausforderung besteht darin, die Datenflut aus den Analysen in klinisch validierte Empfehlungen zu übersetzen.
KI ebnet den Weg in die Zukunft
Die nächste Entwicklungsstufe steht bereits in den Startlöchern. Künstliche Intelligenz wird bei der Analyse komplexer Mikrobiomdaten eine Schlüsselrolle spielen und noch präzisere Vorhersagen ermöglichen.
Forscher entwickeln bereits die nächste Generation von Probiotika, die gezielt für bestimmte Aufgaben „programmiert“ werden könnten. Entzündungen bekämpfen oder spezifische Neurotransmitter produzieren – die Möglichkeiten scheinen grenzenlos.
Es ist durchaus denkbar, dass Mikrobiomanalysen in wenigen Jahren zum Standard bei Gesundheitschecks gehören. Sie könnten eine frühzeitige Risikoerkennung für zahlreiche Krankheiten ermöglichen und die Prävention auf eine neue, datengestützte Ebene heben.
So schätzen die Börsenprofis Aktien ein!

Für. Immer. Kostenlos.